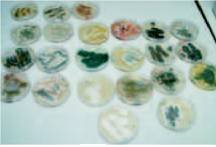

Für einen individuellen Ausdruck passen Sie bitte die
Für einen individuellen Ausdruck passen Sie bitte dieEinstellungen in der Druckvorschau Ihres Browsers an. Regelwerk; BGI / DGUV-I

 Für einen individuellen Ausdruck passen Sie bitte die Für einen individuellen Ausdruck passen Sie bitte dieEinstellungen in der Druckvorschau Ihres Browsers an. Regelwerk; BGI / DGUV-I |
 |
BGI 805 / DGUV Information 209-054 - Tätigkeiten mit biologischen Arbeitsstoffen in der Metallindustrie
Berufsgenossenschaftliche Informationen für Sicherheit und Gesundheit bei der Arbeit (BGI)
(bisher ZH 1/204)
- Dr. Marlies Böhle, Dr. Tomas Glade, Thomas Rabente, Dr. Isabel Warfolomeow -
(Ausgabe 2001; 2005aufgehoben)
| Redaktioneller Hinweis: Berufsgenossenschaften sind gemäß § 210 SGB VII Behörden; ihre amtlichen Veröffentlichungen nach § 15 SGB VII unterliegen gemäß § 5 Abs. 2 UrhG keinem Urheberrechtsschutz. |
implementiert mit Genehmigung der Vereinigung der Metall-Berufsgenossenschaften
Vorwort
In den letzten Jahren sind "biologische Arbeitsstoffe", nicht zuletzt durch zunehmende Problematik beim Sammeln und Recyceln von Wertstoffen, verstärkt in den Blickpunkt der Öffentlichkeit gerückt.
Das darf jedoch nicht darüber hinwegtäuschen, dass Tätigkeiten mit biologischen Stoffen seit langem in sehr vielen und unterschiedlichen Branchen anzutreffen sind, beispielsweise in den Bereichen Forschung und Entwicklung (z.B. Biotechnologie), Gesundheitswesen, Nahrungsmittelproduktion, Landwirtschaft oder Abwasserwirtschaft.
Auch im Bereich der Metallindustrie besteht eine breite Palette an Tätigkeiten mit Kontakt zu Bakterien und Pilzen, z.B. beim Umgang mit wässrigen Umlaufsystemen, wie Kühlschmierstoffen, aber auch bei einer Vielzahl von Wartungs- und Instandhaltungsarbeiten.
Darüber hinaus können auch bei nicht für die Metallindustrie branchentypischen Tätigkeiten, wie Holzbearbeitung oder Abfallwirtschaft, biologische Gefährdungen auftreten.
Zu einem ganzheitlichen Ansatz im Arbeitsschutz gehört auch, den Gefahren durch biologische Arbeitsstoffe vorzubeugen und somit Unfälle, Berufskrankheiten und arbeitsbedingte Gesundheitsgefahren zu verhüten.
Diese BG-Information soll vermitteln,
Aus der betrieblichen Praxis werden eine Reihe von Gefährdungsabschätzungen typischer Arbeitsplätze der Metallindustrie vorgestellt und Möglichkeiten zur Vermeidung oder Verringerung der Gefährdung aufgezeigt.
Die überarbeitete Auflage wurde an die aktuelle Rechtslage angepasst und um weitere relevante Arbeitsbereiche ergänzt.
1 Biologische Arbeitsstoffe
1.1 Was sind biologische Arbeitsstoffe?
1.1.1 Allgemeines
Der Begriff "biologische Arbeitsstoffe" stammt aus der seit April 1999 gültigen Biostoffverordnung (Verordnung über Sicherheit und Gesundheitsschutz bei Tätigkeiten mit biologischen Arbeitsstoffen - BioStoffV).
Als biologische Arbeitsstoffe werden danach vor allem Mikroorganismen, insbesondere
bezeichnet, wenn sie beim Menschen Infektionen, Allergien oder Vergiftungen hervorrufen können.
Auch Viren sind als nicht zelluläre mikrobiologische Einheiten biologische Arbeitsstoffe im Sinne der BioStoffV.
Weitere Gruppen von biologischen Arbeitsstoffen sind
Die verschiedenen Gruppen der biologischen Arbeitsstoffe unterscheiden sich hinsichtlich der Größe (Bild 1-1), des Aufbaus und des Stoffwechsels recht deutlich.
Bild 1-1: Größenordnung von Mikroorganismen (aus BGIA-Handbuch)
| Tierische Zellen | 20-30 µm |
| Bakterienzellen | < 1 µm (Länge 1-5 µm) |
| Luftsporen der Aktinomyzeten | 0,5-1,5 µm |
| Pilzzellen, Pilzfäden |
10 µm |
| Viren | 0,02-0,26 µm |
Wichtige Einflussfaktoren auf das Wachstum von Bakterien und Pilzen sind
Bild 1-2: Mikrobiologische Untersuchung im Labor

Mit mikrobiellem Wachstum muss bereits gerechnet werden, wenn in einem Material geringe Feuchtigkeit vorhanden ist, organisches Material zur Verfügung steht und das Milieu nicht stark sauer oder alkalisch ist.
Wässrige Medien, aber auch sonstiges, feuchtes organisches Material, werden nach Eintrag von Mikroorganismen schnell bewachsen, soweit dies nicht durch spezielle Konservierungsverfahren unterbunden ist.
Quellen für den Eintrag von Mikroorganismen in das Material können u.a. die normale Umgebungsluft, das Trinkwasser oder der Mensch selbst (Hautoberfläche, Sekrete) sein.
1.1.2 Bakterien
Bakterien haben eine Größe von einigen tausendstel Millimetern (Mikrometer, µm). Neben ihrer geringen Größe ist die enorme Wachstumsrate eine charakteristische Eigenschaft. Die Vermehrung der Bakterien erfolgt in der Regel durch Zellteilung. Unter optimalen Bedingungen (ausreichende Nährstoffversorgung und - günstige Temperaturen) kann sich eine Bakterienzelle alle 20 Minuten teilen, sodass theoretisch innerhalb weniger Stunden Millionen von Bakterien aus einer einzigen Zelle hervorgehen können.
Eine weitere bemerkenswerte Eigenschaft ist die unglaubliche Vielfalt an Stoffwechselvorgängen, die von Bakterien ausgeführt werden können.
Während der Mensch auf bestimmte organische Kohlenstoffverbindungen als Energie- und Kohlenstoffquelle (z.B. Zucker, Stärke, tierische und pflanzliche Fette) angewiesen ist, können einige Bakterien eine wesentlich größere Vielfalt chemischer Verbindungen abbauen und zum Überleben nutzen. Cellulose Abis hin zu Mineralöl und einigen Bestandteilen von Kühlschmierstoffen können unter (für die Bakterien) günstigen Umständen abgebaut werden.
Andere Bakterien sind in der Lage, die Oxidation von Eisen- oder Manganionen als Energiequelle zu nutzen. Diese Eigenschaft macht sich bei der so genannten Erz-Laugung (Gewinnung von Schwermetallen als gelöste Salze aus minderwertigem Gestein oder Abraum) zunutze.
Einige Stoffwechselprodukte der Bakterien können für den Menschen Nahrungsmittel (z.B. Milchsäure, Essig) oder aber auch gefährliche Gifte (Lebensmittelvergiftung durch Botulismustoxin, Wundstarrkrampf durch Tetanustoxin) sein.
Der Aufbau der Bakterienzelle unterscheidet sich von dem der Zellen anderer Organismen, beispielsweise der Pilze, höheren Pflanzen und Säugetiere, einschließlich des Menschen, deutlich. Bakterien verfügen u.a. über keinen Zellkern.
Einige Bakterien können beim Menschen Infektionskrankheiten hervorrufen. Mit Hilfe von Antibiotika, die speziell auf bakterielle Zellstrukturen oder Stoffwechselvorgänge wirken, ist eine Bekämpfung von Bakterien im Körper des Menschen möglich, ohne den Menschen zu schädigen.
Außerhalb des menschlichen Körpers können Bakterienzellen mit einer Vielzahl von Bakteriziden (d.h. Bakterien abtötenden Stoffen) bekämpft werden (z.B. Aldehyde, Phenole, Kresole). Diese Stoffe sind aber in der Regel auch für den Menschen schädlich.
Einige Bakteriengruppen sind in der Lage, Sporen zu bilden. Diese Dauerformen dienen dem Überleben der Bakterien bei ungünstigen Umgebungsbedingungen. Bakterielle Endosporen zeigen keine Stoffwechselvorgänge und sind gegenüber Hitze, Trockenheit, UV-Strahlung und Chemikalien oft sehr resistent. Im Gegensatz zu den meisten Bakterienzellen, die bei einer Temperatureinwirkung von 80 °C über 10 Min. (Pasteurisieren) absterben, werden Sporen erst ab Temperaturen über 120 °C abgetötet.
Bakteriensporen können über mehrere Jahrzehnte keimfähig bleiben. Sind die Umgebungsbedingungen für das Wachstum wieder günstig, keimen die Sporen und die Bakterien vermehren sich wieder.
1.1.3 Pilze
Pilzzellen sind meist größer als Bakterien und besitzen einen Zellkern. Schimmelpilze (Bild 1-3) bilden ein Geflecht aus Pilzfäden (Mycel), Hefen wachsen ähnlich wie Bakterien als einzelne Zellen.
Bild 1-3: Auswahl unterschiedlicher Schimmelpilze im Labor
Die Vermehrung der Pilze kann ähnlich den Bakterien durch eine Art Zellteilung (Sprossung, z.B. viele Hefen), Zerbrechen der Pilzfäden oder durch Bildung von Sporen erfolgen. Die mikroskopisch kleinen Pilzsporen werden hauptsächlich - über die Luft verbreitet und sind weniger hitzeresistent als bakterielle Sporen; Austrocknung wird von den meisten Pilzsporen jedoch gut vertragen.
Auch die Pilze sind hinsichtlich der Stoffwechselvorgänge sehr vielseitig. Pilze sind sogar in der Lage, schwer abbaubare natürliche Polymere, wie das Lignin im Holz oder das Chitin des Insektenpanzers, abzubauen.
Die Stoffwechselleistung der Pilze wird seit dem Altertum zur Nahrungsmittelproduktion genutzt (Bier, Wein, Kefir). Aber einige Pilze sind auch in der Lage, gefährliche Toxine zu bilden, z.B. Aflatoxine durch Schimmelpilzarten.
Einige Pilze können darüber hinaus durch ihr Infektionspotenzial und ihre allergenen Eigenschaften eine Gefährdung darstellen.
1.1.4 Sonstige biologische Arbeitsstoffe
Viren
Viren sind mit einer Größe von ca. 0,02 bis 0,3 µm deutlich kleiner als Bakterien und Pilze. Sie sind keine lebenden Organismen, da sie über keinen eigenen Stoffwechsel verfügen. Sie bestehen in der Regel nur aus der Erbinformation, die von einer Eiweißhülle umgeben ist. Erst wenn die Viren in eine Wirtszelle gelangen, werden sie aktiv und führen zu einer Umgestaltung des Zellstoffwechsels. Das führt dazu, dass die infizierte Wirtszelle neue Viruspartikel produziert und in vielen Fällen abstirbt.
Erreger des Rinderwahnsinns (BSE) und verwandter Krankheiten
Die Erreger der eventuell auf den Menschen übertragbaren Form des Rinderwahnsinns und verwandter Krankheiten sind keine Organismen. Wahrscheinlich handelt es sich bei diesen Erregern um eine Art infektiöser Eiweiße, die als Prionen bezeichnet werden.
Endoparasiten
Endoparasiten können sowohl einzellig und mikroskopisch klein als auch vielzellige makroskopische Organismen sein. Diese Organismen stellen keine einheitliche Gruppe dar. Gemeinsam ist ihnen lediglich die Lebensweise als Schmarotzer innerhalb des menschlichen Körpers.
Nach heutigen Erkenntnissen spielen Viren, die Erreger des Rinderwahnsinns und vergleichbarer Krankheiten sowie Endoparasiten als biologische Arbeitsstoffe in der Metallindustrie eine untergeordnete Rolle.
1.1.5 Durch Mikroorganismen gebildete Stoffe
Einige der von Mikroorganismen gebildeten Stoffe können eine Gesundheitsgefahr für den Menschen darstellen.
Hierzu gehören insbesondere
Diese Stoffe sind keine biologischen Arbeitsstoffe im Sinne der BioStoffV. Sie sollen aber dennoch hier betrachtet werden, da ihr Auftreten unmittelbar an das Vorhandensein von Bakterien oder Pilzen gebunden ist.
Zerfallsprodukte von Bakterien und Pilzen
Beim Absterben von Bakterien und Pilzen kommt es zu einem Zerfall der Zellen; gesundheitlich bedeutsam sind vor allem die Zellwandbestandteile Gram-negativer Bakterien. Diese Zellwandbestandteile werden auch als Endotoxine bezeichnet. Sie können entzündliche Prozesse hervorrufen, wenn sie durch Einatmen oder über die Blutbahn in den Körper des Menschen gelangen.
Exotoxine
Als Exotoxine werden die von lebenden Mikroorganismen abgegebenen Giftstoffe bezeichnet. Die Exotoxine werden meist nach Infektion oder oraler Aufnahme wirksam. Im Körper des Menschen können diese Toxine schwere Vergiftungen auslösen. Zu den Exotoxinen gehören beispielsweise das Diphtherietoxin und das Tetanustoxin (Wundstarrkrampf).
Gasförmige Stoffwechselprodukte
Beim Wachstum von Mikroorganismen, auch wenn diese keine Krankheiten hervorrufen, können gasförmige Stoffwechselprodukte freigesetzt werden (z.B. Kohlendioxid, Methan, Schwefelwasserstoff, mikrobielle flüchtige organische Verbindungen [MVOC]). Diese zum Teil geruchsintensiven und/oder toxischen Stoffe gelangen beim Wachstum der Mikroorganismen in die Umgebungsluft. Viele der MVOC sind chemisch gleich oder ähnlich technisch verwendeter Lösemittel.
1.2 Gefährdungen durch biologische Arbeitsstoffe
Eine mögliche Gefährdung durch Mikroorganismen stellt die Infektion dar. Daneben können toxische oder sensibilisierende Wirkungen durch Mikroorganismen oder die von ihnen produzierten Stoffe hervorgerufen werden.
Bei entsprechender beruflicher Exposition kann daraus im Einzelfall sogar eine Berufskrankheit entstehen.
In der BioStoffV werden biologische Arbeitsstoffe in vier unterschiedliche Risikogruppen eingeteilt (siehe Abschnitt 3.1). Diese Klassifizierung erfolgt ausschließlich anhand des Infektionspotenzials.
1.2.1 Infektionen
Neben den Mikroorganismen (vor allem Bakterien), die ständig auf und im gesunden Menschen leben (Haut-, Mund- und Darmflora), lösen einige pathogene (krankmachende) Mikroorganismen Infektionen aus, wenn sie in den menschlichen Organismus eindringen. Andere Mikroorganismen sind opportunistische Krankheitserreger. Diese Organismen sind normalerweise nicht für den Menschen gefährlich, können aber beispielsweise bei einer Abwehrschwäche zu Infektionen führen.
Das Eindringen in den menschlichen Organismus (Eintrittspforten) erfolgt vorwiegend über die Atemwege durch Einatmen erregerhaltiger Luft oder über die Verdauungsorgane durch die Aufnahme kontaminierter Nahrung. Daneben können einige Mikroorganismen über die Schleimhäute (z.B. Nase, Mund, Atemwege, Augen) oder bei Verletzungen der Haut in den Organismus gelangen.
Weiterhin sind insbesondere einige Pilze in der Lage, die Haut zu besiedeln und Mykosen (Pilzinfektionen) auszulösen. Hierbei ist vor allem der Zustand der Haut wichtig. Ständig feuchte oder vorgeschädigte Haut kann Idas Auftreten von Mykosen fördern.
Ob es nach Eindringen von pathogenen Mikroorganismen auch zu einer Infektion kommt, ist vor allem abhängig von der Virulenz der Erreger, der Menge - der eingedrungenen Keime und der Immunabwehr des Menschen.
Bei einem sehr virulenten Erreger können unter Umständen wenige Keime zur Auslösung einer Infektion ausreichen. Bei schwach virulenten Keimen ist eine größere Anzahl notwendig, die in den Körper eindringen muss (Bild 1-4).
Einige Menschen sind darüber hinaus aufgrund des Zustandes ihres Immunsystems empfindlicher gegenüber Infektionen, z.B. Menschen mit schwerer Zuckerkrankheit, bei Cortisoneinnahme, nach einer Organtransplantation oder HIV-infizierte Personen.
Bild 1-4: Infektiöse Keimdosen für unterschiedliche Krankheitserreger

1.2.2 Toxische Wirkungen
Endotoxine können bei Auftreten in Stäuben oder Aerosolen am Arbeitsplatz zu entzündlichen Reaktionen an Schleimhäuten und Atmungsorganen führen. Bei Aufnahme großer Mengen über die Atemwege können spätestens vier bis sechs Stunden nach Exposition bei einigen der exponierten Personen grippeähnliche Symptome beobachtet werden (u.a. Fieber, Kopfschmerz, Husten). Die Symptome klingen in der Regel ein bis zwei Tage nach Ende der Exposition ab. Dieses Beschwerdebild wird auch unter dem Begriff ODTS ("Syndrom durch toxisch wirkende Stäube organischen Materials") zusammengefasst.
Beispielsweise kann die Kühlschmierstoff-Aerosolbildung bei einer Systemreinigung eine Gesundheitsgefahr darstellen. Die nach Absterben der Bakterien freigesetzten Endotoxine gelangen dabei in die Atemluft.
An typischen Arbeitsplätzen in der Metallindustrie haben Messungen ergeben, dass die Belastung durch Endotoxine im Vergleich zu anderen Bereichen (z.B. Massentierhaltung) gering ist. Grenzwerte oder Orientierungswerte sind nicht festgelegt (vgl. ABAS-Bericht "Endotoxine", www.baua.de).
Exotoxine können zu schweren Erkrankungen führen. Die Belastung durch Exotoxine ist an Arbeitsplätzen in der Metallindustrie gegenüber sonstigen Lebensbereichen nicht erhöht.
1.2.3 Sensibilisierung und Allergien
Allergien können sowohl durch chemische als auch durch natürliche Stoffe ausgelöst werden. Nach Aufnahme des Stoffes (Allergen) in den menschlichen Körper reagiert das Immunsystem und es kann zu einer Sensibilisierung kommen. Bei erneutem Kontakt zu dem Allergen kommt es zukünftig dann immer wieder zu den gleichen allergischen Beschwerden.
Neben der Disposition (Bereitschaft, mit einer Allergie zu reagieren) der exponierten Personen ist bei einer Sensibilisierung auch die Dosis des Allergens wichtig. Bei empfindlichen Personen kann eine Sensibilisierung bereits bei niedrigen Dosen erfolgen.
Ist bei einer Person eine Sensibilisierung erfolgt (beispielsweise durch Einatmen von Pilzsporen), kann eine allergische Reaktion dann auch bei Einwirken sehr geringer Mengen des Allergens ausgelöst werden.
Allergische Atemwegserkrankungen können vor allem durch Pilzsporen hervorgerufen werden, wobei sich die Sensibilisierungspotenziale der einzelnen Schimmelpilze unterscheiden: Schimmelpilze mit sensibilisierenden Eigenschaften sind in der TRBa 460 "Einstufung von Pilzen in Risikogruppen" gekennzeichnet.
Bei Bakterien kommen sensibilisierende Wirkungen kaum vor.
Die hervorgerufenen Beschwerden sind dabei auch abhängig von der Größe der Sporen; "große" Sporen (5 bis > 10 µm) verursachen dabei Heuschnupfen-ähnliche Reaktionen der oberen Atemwege oder allergisches Asthma, die "kleineren" (2 bis 4 µm) können bis in die Lungenbläschen vordringen und dort eine allergische Alveolitis (Entzündung der Lungenbläschen) auslösen.
Medizinisch werden die auftretenden Allergien in verschiedene Kategorien eingeteilt; ein wesentliches Unterscheidungskriterium für den Betroffenen ist der Zeitraum zwischen Exposition und Auftreten der Beschwerden (Bild 1-5).
1.2.4 Gefährdungen durch gasförmige Stoffwechselprodukte
Kohlendioxid, Methan und Schwefelwasserstoff sind die am häufigsten von Mikroorganismen gebildeten Gase.
Bild 1-5: Allergietypen und Zeitraum bis zum Auftreten der Symptome
| Allergietyp (nach Gell und Coombs) |
Zeitraum nach Exposition bis zur maximalen Reaktion | Beispiele von Allergieerkrankungen | häufige Symptome |
| Typ I (Soforttyp anaphylaktisch) |
ca. 0,5 Stunden | Heuschnupfen Latexallergie |
Augentränen, Augenjucken, Fließschnupfen |
| Typ III (Soforttyp komplex vermittelt) |
3 - 8 Stunden | exogen allergische Alveolitis: Hausstaubalveolitis, Farmerlunge | Fieber, Schüttelfrost, Atemnot, Husten, Auswurf |
| Typ IV (verzögerter Typ zellvermittelt) |
1 - 2 Tage | Kontaktallergie, z.B. Nickelallergie, Chromatallergie | Hautrötung, Entzündungsreaktionen |
Sie spielen in der Metallindustrie keine bedeutende Rolle. In wenigen Bereichen können sie jedoch eine ernst zu nehmende Gefahr darstellen (z.B. Landtechnik, Klärtechnik); auf mögliche Gefährdungen wird in den speziellen Abschnitten hingewiesen.
Ein Zusammenhang zwischen MVOC ("mikrobielle flüchtige organische Komponenten") am Arbeitsplatz und gesundheitlichen Beeinträchtigungen ist den Berufsgenossenschaften bisher nicht bekannt. Im technischen Bereich ist die Konzentration von MVOC im Vergleich zu den anderen am Arbeitsplatz vorhandenen VOC ("flüchtige organische Komponenten", z.B. Lösemittel) zu vernachlässigen.
Die MVOC haben allenfalls eine Funktion beim Auffinden von baulich bedingtem Schimmelpilzbefall in Innenräumen.
2 Rechtliche Grundlagen
In der betrieblichen Praxis gibt es gelegentlich Abgrenzungsprobleme der BioStoffV zu weiteren Rechtsbereichen. So wird beispielsweise der Aufenthalt in Räumen mit baulichem Schimmelpilzbefall durch das Arbeitsstättenrecht behandelt, da das passive Ausgesetztsein keine Tätigkeit im Sinne der BioStoffV darstellt. Gefahrstoffe, die durch Mikroorganismen gebildet wurden, ohne die Mikroorganismen selbst zu enthalten (z.B. Fäulnisgase, wie Schwefelwasserstoff) fallen in den Geltungsbereich des Gefahrstoffrechts.
2.1 Biostoffverordnung und Technisches Regelwerk
Mit der am 1. April 1999 in Kraft getretenen "Verordnung über Sicherheit und Gesundheitsschutz bei Tätigkeiten mit biologischen Arbeitsstoffen" (Biostoffverordnung - BioStoffV) wurde branchenübergreifend der Arbeitsschutz auf diesem Gebiet neu geregelt.
Gleichzeitig wurde die Europäische Arbeitsschutzrichtlinie 90/679/EWG über den "Schutz der Arbeitnehmer gegen Gefährdungen durch biologische Arbeitsstoffe bei der Arbeit" auf der Grundlage des Artikels 137 des EU-Vertrages als 7. Einzelrichtlinie in nationales Recht umgesetzt. Die kodifizierte Fassung liegt in Form der Richtlinie 2000/54/EG vor.
Die Rechtsgrundlage für die BioStoffV ist das Arbeitsschutzgesetz. Tätigkeiten mit speziellen Gefährdungen werden in Einzelverordnungen konkretisiert. Fielen Tätigkeiten mit biologischen Arbeitsstoffen zuvor in den Geltungsbereich der Gefahrstoffverordnung, so erfolgte nunmehr mit der rechtlichen Neuordnung eine Abgrenzung zum Gefahrstoffrecht.
Erstmalig ist in der BioStoffVein umfassender Ansatz für den präventiven Gesundheitsschutz beim Umgang mit biologischen Arbeitsstoffen enthalten. Mit der BioStoffV wird die Arbeitgeberdefinition des Arbeitsschutzgesetzes um den Unternehmer ohne Beschäftigte ("Ich-AG") erweitert (§ 2 Abs. 8).
Einerseits werden Tätigkeiten berücksichtigt, die direkt auf den biologischen , Stoff ausgerichtet sind (z.B. in biotechnischen Produktionsverfahren). Andererseits werden auch Tätigkeiten, bei denen eine Exposition durchaus möglich ist, die Handhabung der biologischen Arbeitsstoffe aber nicht eigentlicher Zweck der Tätigkeit ist (z.B. Umgang mit wässrigen Kühlschmierstoffen, Arbeiten in Kläranlagen oder an Landmaschinen), geregelt.
Insbesondere die nicht gezielten Tätigkeiten wurden bis zum In-Kraft-Treten der BioStoffV nur unzureichend durch nationale rechtliche Regelungen erfasst (z.B. Chemikaliengesetz, Gefahrstoffverordnung, Unfallverhütungsvorschriften).
Im Zuge der Novellierung der Gefahrstoffverordnung vom 23. Dezember 2004 zur Umsetzung der einschlägigen EG-Richtlinien und zur formalen Angleichung des Aufbaus der Verordnung an das Arbeitsschutzgesetz sind zeitgleich auch Änderungen der BioStoffV als Rechtsangleichung erforderlich geworden. Wesentliche Änderungen betreffen die Gefährdungsbeurteilung, die Unterrichtung der Beschäftigten sowie die verpflichtenden arbeitsmedizinischen Vorsorgeuntersuchungen.
Es entfällt die Pflicht der jährlichen Aktualisierung der Gefährdungsbeurteilung. Die bisher explizit vorgeschriebene Beteiligung des Betriebs-/Personalrates an der Gefährdungsbeurteilung wurde aus der BioStoffV herausgenommen, da die Beteiligung bereits im Betriebsverfassungsgesetz geregelt ist.
Der Arbeitgeber hat sich bei der Gefährdungsbeurteilung fachkundig beraten zu lassen, sofern er nicht selbst über die erforderlichen Kenntnisse verfügt. Die Beratung hat durch den Betriebsarzt oder die Fachkraft für Arbeitssicherheit zu erfolgen (Näheres siehe Abschnitt 3.1).
Die arbeitsmedizinische Vorsorge hat bei der Novelle der BioStoffV noch an Bedeutung gewonnen. Die bisherige arbeitsmedizinische Vorsorge wurde neu gefasst und um eine allgemeine arbeitsmedizinische Beratung erweitert. Näheres hierzu ist in Abschnitt 4 ausgeführt.
Die Anforderungen aus der BioStoffV werden in Technischen Regeln für biologische Arbeitsstoffe ( TRBA) konkretisiert.
Die Technischen Regeln werden vom Ausschuss für biologische Arbeitsstoffe (ABAS) oder im Kooperationsmodell mit den Berufsgenossenschaften erarbeitet. Die Gliederung des Technischen Regelwerks erfolgt ähnlich dem Gefahrstoffbereich.
Bild 2-1: Übersicht über Technische Regeln für biologische Arbeitsstoffe
| TRBA 001 - 099 |
Allgemeines, Aufbau und Anwendung |
| TRBA 100 - 299 |
Tätigkeiten mit biologischen Arbeitsstoffen |
| TRBA 300 - 399 |
Arbeitsmedizinische Vorsorge |
| TRBA 400 - 499 |
Arbeitsplatzbewertung |
| TRBA 500 - 599 |
Hygiene- und Desinfektionsmaßnahmen |
| TRBA 600 - 699 |
Sonstige Bekanntmachungen des ABAS |
Eine Übersicht über die derzeit erlassenen TRBa ist im Literaturverzeichnis (Abschnitt 7) enthalten.
2.2 BG-Regelwerk - Unfallverhütungsvorschrift "Biologische Arbeitsstoffe"
(BGV B12 - aufgehoben zum 01.01.2004)
Zur Schaffung von mehr Rechtsklarheit für den Unternehmer wurden mit In-Kraft-Treten der neuen Unfallverhütungsvorschrift "Grundsätze der Prävention" (BGV A1) Doppelregelungen im staatlichen und berufsgenossenschaftlichen Regelwerk beseitigt.
Zahlreiche Unfallverhütungsvorschriften, darunter auch "Biologische Arbeitsstoffe" (BGV B12), konnten somit aufgehoben werden. Das staatliche Arbeitsschutzrecht wird hier in Bezug genommen und findet somit gleichermaßen im berufsgenossenschaftlichen Bereich Anwendung.
Die ehemals in § 3 Abs. 1 der BGV B12 aufgeführten zusätzlichen Pflichten für den Unternehmer hinsichtlich der Gefährdungsermittlung und der Festlegung von Schutzmaßnahmen bei Beauftragung von Fremdunternehmen sind nunmehr in den §§ 5 und 6 der BGV A1 geregelt (siehe Abschnitt 3.4).
Darüber hinaus existieren eine Vielzahl von = BG-Regeln und BG-Informationen sowie branchen- oder arbeitsplatzbezogene Schriften der Unfallversicherungsträger, die sich entweder hauptsächlich mit biologischen Gefährdungen befassen oder diese als Teilaspekte behandeln. Diese liefern wichtige und hilfreiche Informationen bei der Durchführung der Gefährdungsbeurteilung und in der Festlegung der erforderlichen Schutzmaßnahmen.
Eine Auflistung der Schriften findet sich in Abschnitt 7.
3 Gefährdungsbeurteilung
Der Unternehmer ist nach § 5 Arbeitsschutzgesetz ( ArbSchG) verpflichtet, die unterschiedlichen arbeitsplatzbedingten Gefährdungen Beschäftigten zu ermitteln und entsprechende Schutzmaßnahmen zu treffen.
Für Tätigkeiten mit biologischen Arbeitsstoffen muss er dabei nach der BioStoffV vorgehen. Die detaillierte Vorgehensweise beschreibt die TRBa 400 "Handlungsanleitung zur Gefährdungsbeurteilung bei Tätigkeiten mit biologischen Arbeitsstoffen".
Bild 3-1: Biologische Arbeitsstoffe als Teil der Beurteilung der Arbeitsbedingungen nach § 5 ArbSchG

Im Rahmen der umfassenden Gefährdungsbeurteilung nach ArbSchG müssen die Ergebnisse der Beurteilungen der einzelnen Gefährdungen zusammengefasst und die zu treffenden Schutzmaßnahmen aufeinander abgestimmt werden (Bild 3-1).
In dieser BG-Information werden Hilfen zur Gefährdungsbeurteilung und Empfehlungen zur Festlegung geeigneter Schutzmaßnahmen für metallbranchentypische Tätigkeiten mit einer möglichen Belastung durch biologische Arbeitsstoffe gegeben.
3.1 Durchführung der Gefährdungsbeurteilung
Die Gefährdungsbeurteilung nach BioStoffV ist vom Unternehmer unter Beachtung der Vorgaben des Betriebsverfassungsgesetzes durchzuführen.
Verfügt er dabei nicht selbst über die nötige Fachkunde, muss er sich fachkundig beraten lassen, z.B. durch Beteiligung des Betriebsarztes und der Fachkraft für Arbeitssicherheit.
Die Gefährdungsbeurteilung ist
Sie ist zu wiederholen
Grundlage für die Gefährdungsbeurteilung ist die Beschaffung von unterschiedlichen Informationen zu den Tätigkeiten und den biologischen Arbeitsstoffen (z.B. Einstufung in Risikogruppen). Ausgehend hiervon muss die Entscheidung getroffen werden, ob es sich um eine "gezielte" oder um eine "nicht gezielte" Tätigkeit handelt.
Anschließend muss die Tätigkeit einer von vier Schutzstufen zugeordnet werden, aus denen sich dann die zu treffenden Schutzmaßnahmen ableiten lassen. Mit der Festlegung der Maßnahmen muss auch die Überprüfung der Wirksamkeit sichergestellt werden.
Abschließend ist die Gefährdungsbeurteilung zu dokumentieren (vgl. Abschnitt 3.3).
Bild 3-2: Ablauf der Gefährdungsbeurteilung nach BioStoffV

Einstufung von biologischen Arbeitsstoffen
Die BioStoffV teilt die biologischen Arbeitsstoffe in vier Risikogruppen ein. Die Einstufung eines biologischen Arbeitsstoffes in eine Risikogruppe erfolgt ausschließlich nach dem Infektionspotenzial (vgl. Abschnitt 1.2.1); toxische oder allergene Wirkungen (vgl. Abschnitte 1.2.2 und 1.2.3) werden hierbei nicht berücksichtigt.
Die Risikogruppe ergibt sich aus der Schwere einer möglichen Erkrankung, der Ansteckungsgefahr sowie der Möglichkeit, durch Vorbeugung (z.B. Impfung) oder Behandlung eine Infektion zu vermeiden bzw. infizierte Personen zu heilen (Bild 3-3).
Bild 3-3: Risikogruppen für biologische Arbeitsstoffe
 |
Risikogruppe | Krankheit | Gefahr für Beschäftigte | Verbreitung in der Bevölkerung | Vorbeugung/Behandlung möglich |
| 1 | unwahrscheinlich | gering | nein | nicht erforderlich | |
| 2 | möglich | möglich | unwahrscheinlich | ja | |
| 3 | möglich, schwer | ernsthaft | möglich | ja | |
| 4 | ja, schwer | ernsthaft | u.U. groß | nein |
Die rechtsverbindlichen Einstufungen biologischer Arbeitsstoffe der Risikogruppen 2 bis 4 sind im Anhang III der Richtlinie 90/679/EWG in Verbindung mit den jeweils gültigen Änderungs- und Anpassungsrichtlinien (kodifizierte Fassung: Richtlinie 2000/54/EG) veröffentlicht.
Ergänzend hierzu enthalten die Einstufungen:
Die toxischen und sensibilisierenden Wirkungen biologischer Arbeitsstoffe müssen zusätzlich ermittelt werden. Hinweise hierzu können im Einzelfall dem Anhang III der RL 90/679/EWG und deren Änderungsrichtlinien (kodifizierte Fassung: RL 2000/54/EG) durch eine Kennzeichnung mit a (= allergisierend) oder T (= toxisch) entnommen werden. Darüber hinaus finden sich Hinweise auf sensibilisierende Eigenschaften biologischer Arbeitsstoffe auch im ABAS-Beschluss 606 "Biologische Arbeitsstoffe mit sensibilisierender Wirkung" und in den folgenden Technischen Regeln für Gefahrstoffe:
Für die Gefährdungsbeurteilung ist es weiterhin erforderlich, die Übertragungswege der ermittelten biologischen Arbeitsstoffe zu kennen (beispielsweise Schmierinfektion, Tröpfcheninfektion).
3.1.1 Informationsbeschaffung
Zunächst müssen Informationen beschafft und gesammelt werden, hierzu zählen nach § 5 BioStoffV vor allem
Gerade bei den in der Metallbranche anfallenden Tätigkeiten mit biologischen - Arbeitsstoffen können die Informationen häufig nicht zu allen aufgeführten Punkten beschaffbar sein, da z.B. nur selten die vorkommenden Mikroorganismen - bis zur Art bekannt sind.
In diesen Fällen muss geprüft werden, welche Mikroorganismen oder Gruppen von Mikroorganismen für die zu beurteilenden Tätigkeiten relevant sind; hierbei spielen neben der Identität auch die Wahrscheinlichkeit und die Art des Auftretens (z.B. luftgetragen, an Oberflächen gebunden) der Mikroorganismen eine Rolle.
Als Informationen sollten auch die tätigkeitsrelevanten betriebseigenen Erfahrungen sowie die entsprechenden betrieblichen Unterlagen, z.B. Berichte aus den Arbeitsschutzausschusssitzungen, Unfallmeldebogen, Berufskrankheiten-Verdachtsmeldungen und ggf. vorliegende innerbetriebliche Unterlagen zu Messungen herangezogen werden.
In einzelnen Fällen können die Informationen über die biologischen Arbeitsstoffe (§ 5 Abs. 1 Nr. 1 BioStoffV) - z.B. bei Instandhaltungsarbeiten an biotechnischen Anlagen - über deren Betreiber ermittelt werden. Für die meisten Tätigkeiten sind diese Daten aber für jeden einzelnen Unternehmer nur schwer beschaffbar. Hier soll diese BG-Information weiterhelfen, aber auch die im Literaturverzeichnis aufgelisteten Informationsschriften anderer Institutionen.
Sollten sich die gewünschten Informationen dort nicht finden, können externe Fachkundige hinzugezogen werden, wie sie beispielsweise bei Berufsgenossenschaften, den Staatlichen Ämtern für Arbeitsschutz/Gewerbeaufsichtsämtern oder auch bei Kammern und Verbänden vorhanden sind.
3.1.2 Entscheidung: Gezielte/nicht gezielte Tätigkeiten
Die BioStoffV unterscheidet zwischen gezielten und nicht gezielten Tätigkeiten (Bild 3-4).
Gezielte Tätigkeiten liegen vor, wenn
Bild 3-4: Entscheidung "Gezielte oder nicht gezielte Tätigkeit"

Wenn bereits eine oder auch mehrere dieser Voraussetzungen nicht erfüllt sind, handelt es sich um eine nicht gezielte Tätigkeit im Sinne der BioStoffV (§ 2 Abs. 5). Typisches Beispiel für eine gezielte Tätigkeit ist das Beimpfen eines Fermenters für die biotechnische Produktion eines Medikamentes, Beispiel für eine nicht gezielte Tätigkeit ist die Arbeit an einer Abfallsortieranlage.
Die Entscheidung "gezielt" oder "nicht gezielt" hat keinen Einfluss auf das Schutzniveau, obwohl sich die Gefährdungsbeurteilung und die Festlegung der Schutzmaßnahmen bei gezielten und nicht gezielten Tätigkeiten unterscheiden.
In der Metallindustrie überwiegen die nicht gezielten Tätigkeiten mit biologischen Stoffen bei weitem. Die Tätigkeiten sind in der Regel auch dadurch gekennzeichnet, dass eine wechselnde Mischexposition mit biologischen Arbeitsstoffen unterschiedlicher Risikogruppen (meist Risikogruppe 1 und 2) vorliegt.
3.1.3 Zuordnung der Tätigkeit zu einer Schutzstufe
Die Zuordnung einer Tätigkeit zu einer der vier durch die BioStoffV vorgegebenen Schutzstufen erfolgt durch eine Abschätzung der Höhe der Infektionsgefährdung. Die Schutzstufen und die daraus folgenden Hygiene- und Sicherheitsmaßnahmen sind in den Anhängen II und III der BioStoffV aufgeführt.
Die Höhe der Infektionsgefährdung wird insbesondere bestimmt durch
Nicht gezielte Tätigkeiten mit biologischen Arbeitsstoffen, bei denen keine Infektionsgefährdung besteht bzw. diese unwahrscheinlich ist, sind vergleichbar mit gezielten Tätigkeiten mit biologischen Arbeitsstoffen der Risikogruppe 1 und somit der Schutzstufe 1 zuzuordnen.
Nicht gezielte Tätigkeiten, bei denen die Gefährdung maßgeblich durch biologische Arbeitsstoffe der Risikogruppe 2 bestimmt wird, sind in der Regel der Schutzstufe 2 zuzuordnen. Entsprechendes gilt für eine Zuordnung zu Schutzstufe 3 (derartige Tätigkeiten sind bislang in der Metallbranche nicht bekannt).
Anders als bei gezielten Tätigkeiten, bei denen sich die Schutzstufenzuordnung immer aus den Mikroorganismen der höchsten Risikogruppe ergibt, kann bei nicht gezielten Tätigkeiten auch eine niedrigere Schutzstufe gewählt werden, wenn eine Gefährdung durch die biologischen Arbeitsstoffe der höchsten Risikogruppe aufgrund der Expositionssituation unwahrscheinlich ist.
In der Regel kann auch eine nicht gezielte Tätigkeit einer Schutzstufe zugeordnet werden. Liegen im Einzelfall keine ausreichenden Informationen und Erkenntnisse vor, sodass keine Zuordnung zu einer Schutzstufe vorgenommen werden kann, ist entsprechend § 7 Abs. 3 BioStoffV (Ermittlung und Festlegung der Schutzmaßnahmen nach dem Stand der Technik) zu verfahren. Dies kann z.B. bei neuen Verfahren und Techniken der Fall sein.
Das Vorgehen bei der Gefährdungsbeurteilung ist hier vom konkreten Einzelfall abhängig und erfordert vom Unternehmer einen erhöhten Aufwand bei der Beschaffung der Informationen sowie bei der Festlegung der erforderlichen Schutzmaßnahmen.
Zusätzlich zur Infektionsgefährdung müssen die toxischen und sensibilisierenden Wirkungen der biologischen Arbeitsstoffe bei der Beurteilung berücksichtigt werden. Diese Wirkungen haben zwar keinen Einfluss auf die Zuordnung zu einer Schutzstufe, erfordern aber ggf. weiter gehendeSchutzmaßnahmen.
3.2 Festlegung von Maßnahmen
Grundsätzlich sind Beschäftigte, die Tätigkeiten ausüben, bei denen sie biologischen Arbeitsstoffen ausgesetzt sind, durch geeignete Maßnahmen zu schützen.
Generell wird in der BioStoffV zwischen
unterschieden.
Der Unternehmer hat auf der Grundlage der Ergebnisse der Gefährdungsbeurteilung und unter Berücksichtigung der genannten Vorschriften Schutzmaßnahmen festzulegen.
Die in den Anhängen II und III BioStoffV aufgeführten Sicherheitsmaßnahmen sind jedoch vorwiegend auf gezielte Tätigkeiten ausgerichtet und auf (nicht gezielte) Tätigkeiten in der Metallbranche nur selten anwendbar. Die Schutz-/Hygienemaßnahmen nach §§ 10 und 11 der BioStoffV und die in der TRBa 500 beschriebenen allgemeinen Hygienemaßnahmen sind hingegen auch in diesen Bereichen geeignet, eine Gefährdung der Beschäftigten zu verringern.
3.2.1 Rangfolge der Schutzmaßnahmen
Tätigkeiten mit biologischen Arbeitsstoffen der Risikogruppen 2, 3 und 4 unterliegen zuerst einem Substitutionsgebot (§ 10 Abs. 2 BioStoffV ), d.h. auf der Grundlage der Gefährdungsermittlung ist zu prüfen, ob ggf. unbedenklichere biologische Stoffe eingesetzt werden können oder ob durch Wahl eines anderen Arbeitsverfahrens/-mittels eine geringere gesundheitliche Gefährdung erreicht werden kann.
Da im Bereich der Metallindustrie fast ausschließlich nicht gezielte Tätigkeiten mit biologischen Arbeitsstoffen durchgeführt werden, ergibt sich in der Regel auch keine Ersatzmöglichkeit für den biologischen Arbeitsstoff.
Bei der Rangfolge der Maßnahmen gilt das aus dem Gefahrstoffrecht hinlänglich bekannte abgestufte Konzept mit technischen, organisatorischen und persönlichen Maßnahmen.
3.2.2 Hygienemaßnahmen
Bei allen Tätigkeiten (gezielt und nicht gezielt) mit biologischen Arbeitsstoffen sind grundsätzlich als Mindestforderung die allgemeinen Hygienemaßnahmen der Schutzstufe 1 nach TRBa 500 "Allgemeine Hygienemaßnahmen: Mindestanforderungen" einzuhalten.
Folgende Aspekte werden u.a. geregelt:
Gerade der Einhaltung der allgemeinen Hygieneregeln kommt im Arbeitsschutz bei Tätigkeiten mit biologischen Arbeitsstoffen eine besondere Bedeutung zu.
3.2.3 Weitere Schutzmaßnahmen
Ist die Tätigkeit der Schutzstufe 2 oder darüber zuzuordnen, müssen über die allgemeinen Hygieneregeln hinausgehende Schutzmaßnahmen getroffen werden. Möglichkeiten der Minimierung von gesundheitlichen Gefährdungen sind z.B.
Je nach Ergebnis der Gefährdungsbeurteilung kann es ggf. erforderlich sein, weitere Schutzmaßnahmen zu treffen:
Bild 3-5: Symbol für Biogefährdung

Bei sehr vielen nicht gezielten Tätigkeiten müssen auch allergene und toxische Wirkungen bei der Festlegung von Maßnahmen berücksichtigt werden. Oft wird eine Verminderung der Gefährdung durch biologische Arbeitsstoffe auch durch Maßnahmen zum Schutz vor Gefahrstoffen erreicht.
Der Unternehmer darf Beschäftigten gezielte/nicht gezielte Tätigkeiten mit biologischen Arbeitsstoffen der Risikogruppen 3 und 4 nur übertragen, wenn diese ausreichend fachkundig und eingewiesen sind. Hier ist zusätzlich die Aufstellung eines Notfallplans zwingend erforderlich.
3.2.4 Überprüfung der Wirksamkeit der Schutzmaßnahmen
In der Gefährdungsbeurteilung sind zwar in der Regel geeignete Schutzmaßnahmen festgelegt worden, ihre Wirksamkeit ist jedoch häufig nicht oder nicht mehr gegeben. Der regelmäßigen Überprüfung von Funktion und Wirksamkeit der Schutzmaßnahmen kommt daher in der Praxis eine besondere Bedeutung zu.
Hierfür ist es zunächst wichtig, einen Verantwortlichen festzulegen. Die eigentliche Überprüfung der Wirksamkeit der Schutzmaßnahmen kann - je nach Anwendungsfall - sehr unterschiedlich ausfallen. Parameter zur Beurteilung können beispielsweise sein:
Die Kontrolle kann daher auch häufig aufgrund recht einfach und optisch zu beurteilender Parameter erfolgen und setzt keineswegs Messungen voraus. Im Technischen Regelwerk ist sogar nur ein einziger "Technischer Kontrollwert" (TKW) zur Überprüfung der Wirksamkeit von technischen Schutzmaßnahmen aufgestellt worden, und zwar für Kompostieranlagen (TRBa 211).
Ist für einen Bereich eine TRBa erstellt worden, können hieraus konkrete Hinweise zu geeigneten Überprüfungsmethoden entnommen werden.
3.2.5 Betriebsanweisung, Unterweisung und arbeitsmedizinische Beratung
Der Unternehmer hat auf der Grundlage der Gefährdungsbeurteilung vor Aufnahme der Tätigkeit arbeitsbereichs- und stoffbezogene Betriebsanweisungen zu erstellen (§ 12 BioStoffV).
Die Betriebsanweisung soll die Beschäftigten informieren über
Besteht an einem Arbeitsplatz sowohl Umgang mit einem Gefahrstoff als auch mit einem biologischen Arbeitsstoff, sollte eine gemeinsame Betriebsanweisung erstellt werden.
Die Betriebsanweisung ist in einer für den Beschäftigten verständlichen Form und Sprache abzufassen und an geeigneter Stelle in der Arbeitsstätte bekannt zu machen.
Die BG-Information "Betriebsanweisungen nach der Biostoffverordnung" (BGI 853) enthält Musterbetriebsanweisungen für typische branchenspezifische nicht gezielte Tätigkeiten mit biologischen Arbeitsstoffen.
Für Arbeitsbereiche mit erfahrungsgemäß erhöhtem Infektions- oder Unfallrisiko (z.B. bei Instandhaltungs-, Reinigungs- oder Abbrucharbeiten in oder an kontaminierten Anlagen, Geräten oder Einrichtungen) fordert die BioStoffV (§ 12 Abs. 3) ausdrücklich zusätzlich Arbeitsanweisungen mit konkreten Hinweisen zur Reduzierung der Unfallgefahr.
Die Beschäftigten sind anhand der Betriebsanweisung gemäß § 14 Arbeitsschutzgesetz und § 12 Abs. 2 BioStoffV über die auftretenden Gefahren sowie über die Schutzmaßnahmen mündlich und arbeitsplatzbezogen zu unterweisen. Die Beschäftigten sind insbesondere über die Notwendigkeit der Einhaltung der allgemeinen Hygieneregeln am Arbeitsplatz als wichtiger Faktor zur Minderung der gesundheitlichen Gefährdung aufzuklären.
Erstmalig schreibt die novellierte BioStoffV (§ 12 Abs. 2a) im Rahmen der Unterweisung auch eine allgemeine arbeitsmedizinische Beratung für alle Beschäftigten, die Tätigkeiten mit biologischen Arbeitsstoffen durchführen, vor. Die Beschäftigten sollen dabei insbesondere über die Möglichkeit von Angebotsuntersuchungen, Impfmöglichkeiten und mögliche individuelle Gefährdungen (z.B. dauernd verminderte Immunabwehr) informiert werden (siehe auch Abschnitt 4 "Arbeitsmedizinische Vorsorge").
Die Unterweisung der Beschäftigten muss vor Aufnahme der Tätigkeit durchgeführt und in Folge jährlich überprüft werden. Bei Änderung der Arbeitsbedingungen, die zu einer erhöhten Gefährdung der Beschäftigten führen können, hat erneut eine Unterweisung zu erfolgen.
Bild 3-6: Musterbetriebsanweisung - BGI 853

Weitere Gründe für eine vorgezogene Unterweisung vor Ablauf der Jahresfrist sind:
Der Unterwiesene muss die erhaltene Unterweisung durch persönliche Unterschrift bestätigen, wobei Inhalt und Zeitpunkt ebenfalls schriftlich festzuhalten sind.
3.3 Dokumentation
Nach § 8 BioStoffV muss die Gefährdungsbeurteilung dokumentiert werden.
Die Dokumentationsunterlagen müssen mindestens enthalten:
Zu den Unterlagen gehört bei nicht gezielten Tätigkeiten die Angabe der relevanten Mikroorganismen oder Mikroorganismengruppen, bei gezielten Tätigkeiten auch ein Verzeichnis der biologischen Arbeitsstoffe.
3.4 Beauftragung von Fremdunternehmen
Durch die Koordination bei Zusammenarbeit mehrerer Arbeitgeber (§ 8 ArbSchG, § 6 Unfallverhütungsvorschrift "Grundsätze der Prävention" [BGV A1]) sollen diese Probleme minimiert werden.
Die Gefährdungsbeurteilung für die Instandhaltungsarbeiten muss von dem ausführenden Unternehmen (Fremdfirma) erstellt werden. Der Auftrag erteilende Unternehmer (Kunde) ist aber gemäß BGV A1 (§ 5 Abs. 3) zur Hilfe bei der Ermittlung der betriebsspezifischen Gefahren verpflichtet.
Mitgliedsbetriebe, die als Fremdfirmen Instandhaltungsarbeiten bei Kunden ausführen, sollten von den Kunden vor Arbeitsaufnahme eine Auskunft hinsichtlich einer Gefährdung ihrer Monteure durch biologische (und andere) Arbeitsstoffe verlangen. Eine entsprechende Auskunftspflicht könnte beispielsweise schon in der Auftragsgestaltung berücksichtigt werden.
Auch die Benutzung bestimmter Einrichtungen beim Kunden durch die Monteure (z.B. Waschgelegenheiten, Duschen, Umkleideschränke, Abfallsammelbehälter usw.) sollte vor Beginn der Instandhaltungsarbeiten entsprechend den in der Gefährdungsbeurteilung für die durchzuführenden Arbeiten für erforderlich bestimmten Maßnahmen geregelt sein.
Technische und organisatorische Maßnahmen gegen die ermittelte Gefährdung sollen vorrangig getroffen werden. Da Fremdfirmen aber oft wenig Einfluss auf die technischen (insbesondere baulichen) Einrichtungen beim Kunden nehmen können, y kommt den persönlichen Schutzausrüstungen (PSA) besondere Bedeutung zu.
Teilweise müssen Instandhaltungsarbeiten an Orten ausgeführt werden, an denen Einrichtungen für grundlegende hygienische Maßnahmen nicht zur Verfügung stehen (teilweise im außereuropäischen Ausland) oder nicht genutzt werden können (private Haushalte). Oder die Instandhaltungsarbeiten müssen aufgrund der betriebsspezifischen Situation extrem kurzfristig erfolgen.
Monteure, die unter o.g. Bedingungen in kontaminierten Bereichen arbeiten müssen, sollten durch Unterweisungen und durch mitgeführte PSa selbst in die Lage versetzt werden, die notwendigen Hygienemaßnahmen durchzuführen. Bewährt hat sich die Zusammenstellung von möglicherweise benötigten PSa und weiterer Hygieneartikel (z.B. Desinfektionsmittel, wasserloser Handreiniger usw.) in einem "Hygienekoffer".
Bei der Beauftragung von Fremdunternehmen muss der Auftrag erteilende Unternehmer zusätzliche Pflichten gemäß § 8 ArbSchG und §§ 5 und 6 BGV A1 beachten.
So hat er das Fremdunternehmen bei der Gefährdungsbeurteilung bezüglich der betriebsspezifischen Gefahren zu unterstützen. Bei der Gefährdungsermittlung und -beurteilung sind sowohl eigene Beschäftigte als auch die Beschäftigten des Fremdunternehmens gemeinsam zu berücksichtigen und die erforderlichen Maßnahmen festzulegen.
Maßnahmen und Festlegungen sind vom Auftraggeber und Auftragnehmer gemeinsam in schriftlicher Form zu dokumentieren.
In Abstimmung mit dem Fremdunternehmer ist eine Person mit Weisungsbefugnis schriftlich zu bestellen.
Der Auftraggeber hat sich zu vergewissern, dass Personen, die in seinem Betrieb tätig werden, hinsichtlich der Gesundheits- und Sicherheitsgefahren während ihrer Tätigkeit angemessene Anweisungen erhalten haben.
3.5 Anzeige-, Aufzeichnungs- und Informationspflichten
Die Beschäftigten und der Betriebsrat sind über Betriebsstörungen oder Unfälle, welche die Gesundheit der Beschäftigten gefährden können, unverzüglich zu unterrichten.
Darüber hinaus sieht die BioStoffV für gezielte Tätigkeiten der Schutzstufe 2, 3 oder 4 und für nicht gezielte Tätigkeiten der Schutzstufe 3 oder 4 eine Anzeige- und Aufzeichnungspflicht vor (§ 13 BioStoffV).
4 Arbeitsmedizinische Vorsorge
Die arbeitsmedizinische Vorsorge beschränkt sich nicht nur auf die Durchführung von Vorsorgeuntersuchungen. Vielmehr muss der Betriebsarzt bereits im Zuge der Primärprävention bei der Gefährdungsbeurteilung und der Festlegung geeigneter Schutzmaßnahmen beteiligt werden (vgl. Abschnitt 3).
Arbeitsmedizinische Vorsorgeuntersuchungen umfassen nach BioStoffV
Pflichtuntersuchungen
Der Unternehmer muss Beschäftigte bei gezielten oder nicht gezielten Tätigkeiten der Schutzstufe 4 arbeitsmedizinisch untersuchen lassen, weiterhin bei den im Anhang IV der BioStoffV genannten Bereichen und Tätigkeiten. Für die meisten Tätigkeiten in der Metallbranche sind Pflichtuntersuchungen nicht erforderlich. Vorgeschrieben sind sie bei bestimmten Tätigkeiten, z.B. in den Bereichen "Kläranlagen/Kanalisation" und "Notfall- und Rettungsdienste". Hierbei ist zu berücksichtigen, dass die Gefahr einer Infektion bei den Beschäftigten deutlich höher sein muss als bei der Allgemeinbevölkerung.
Die Durchführung der Pflichtuntersuchungen ist Voraussetzung für die Beschäftigung oder Weiterbeschäftigung mit der entsprechenden Tätigkeit. Für Beschäftigte, die einer Pflichtuntersuchung unterliegen, ist vom Arbeitgeber eine Vorsorgekartei zu führen. Beim Ausscheiden aus dem Betrieb ist dem Beschäftigten der ihn betreffende Auszug aus der Kartei auszuhändigen; der Arbeitgeber bewahrt eine entsprechende Kopie des Auszugs auf.
Angebotsuntersuchungen
Bei gezielten oder nicht gezielten Tätigkeiten mit biologischen Arbeitsstoffen der Schutzstufe 3 muss der Unternehmer den Beschäftigten eine Untersuchung anbieten. Die Beschäftigten müssen dieses Angebot nicht annehmen; die Untersuchung ist nicht Voraussetzung für die Weiterbeschäftigung.
Diese Angebotspflicht seitens des Unternehmers zur Untersuchung gilt prinzipiell auch für Tätigkeiten in der Schutzstufe 2, - es sei denn, aufgrund der Gefährdungsbeurteilung und der getroffenen Schutzmaßnahmen ist nicht von einer Infektionsgefährdung auszugehen.
Formen und Umfang der arbeitsmedizinischen Vorsorge
Die arbeitsmedizinischen Vorsorgeuntersuchungen werden vom Arbeitgeber veranlasst oder angeboten als
Der Arbeitgeber darf für die arbeitsmedizinische Vorsorge nur Ärzte beauftragen, die Fachärzte für Arbeitsmedizin sind oder die Zusatzbezeichnung "Betriebsmedizin" führen, eine spezielle "Ermächtigung" ist hierfür nicht vorgesehen. Der beauftragte Arzt sollte in der Regel der Betriebsarzt nach § 2 des Arbeitssicherheitsgesetzes sein.
Für arbeitsmedizinische Vorsorgeuntersuchungen, die besondere Fachkenntnisse oder eine spezielle Ausrüstung erfordern, sind Ärzte hinzuzuziehen, die diese Anforderungen erfüllen (z.B. Fachärzte für Tropenmedizin).
Arbeitsmedizinische Vorsorgeuntersuchungen umfassen in der Regel
und setzen die Kenntnis des Arbeitsplatzes durch den Arzt voraus.
Die Untersuchungsergebnisse müssen dokumentiert werden.
Der Unternehmer erhält nur bei den Pflichtuntersuchungen, nicht jedoch bei den Angebotsuntersuchungen eine Bescheinigung über das Ergebnis. Die untersuchte Person muss in jedem Fall über den Untersuchungsbefund unterrichtet werden.
Arbeitsmedizinische Vorsorgeuntersuchungen müssen nicht durchgeführt werden, wenn der Beschäftigte über einen ausreichenden Immunschutz (z.B. durch eine noch wirksame Impfung) gegenüber dem biologischen Arbeitsstoff verfügt. Gleiches gilt für das Führen einer Vorsorgekartei bei Pflichtuntersuchungen. Ansonsten hat der Arbeitgeber zu veranlassen, dass dem Beschäftigten im Rahmen der arbeitsmedizinischen Vorsorgeuntersuchung die entsprechende Impfung angeboten wird, wenn ein wirksamer Impfschutz zur Verfügung steht.
Impfempfehlungen werden auch von der "Ständigen Impfkommission am Robert-Koch-Institut" (STIKO) herausgegeben. Der Beschäftigte ist über den Nutzen der Impfung, mögliche Nebenwirkungen oder Komplikationen aufzuklären. Die Kosten der Impfung hat grundsätzlich der Unternehmer zu tragen. Lehnt der Beschäftigte das Impfangebot ab, ist dies allein kein Grund gesundheitliche Bedenken gegen die Ausübung einer Tätigkeit auszusprechen.
Entscheidungshilfen, für welche Tätigkeitsbereiche arbeitsmedizinische Untersuchungen anzubieten sind, geben bis auf weiteres die bisherigen Auswahlkriterien nach den Berufsgenossenschaftlichen Grundsätzen (z.B. BG-Information "Auswahlkriterien für die spezielle arbeitsmedizinische Vorsorge nach den Berufsgenossenschaftlichen Grundsätzen für arbeitsmedizinische Vorsorgeuntersuchungen - Infektionskrankheiten" nach dem Berufsgenossenschaftlichen Grundsatz G 42 "Tätigkeiten mit Infektionsgefährdung" [BGI 504-42]).
Bei Gefährdungen durch sensibilisierende oder toxische Eigenschaften der Mikroorganismen können zusätzlich arbeitsmedizinische Untersuchungen nach der GefStoffV gemäß den Empfehlungen der BG-Grundsätze G 23 "Obstruktive Atemwegserkrankungen" und G 24 "Hauterkrankungen" notwendig werden, bei einem Arbeitsaufenthalt im Ausland auch nach G 35 "Arbeitsaufenthalt im Ausland unter besonderen klimatischen und gesundheitlichen Belastungen" (siehe Abschnitt 5.5.1).
Darüber hinaus werden zukünftig in der TRBa 300 "Arbeitsmedizinische Vorsorge" (in Vorbereitung) und der BG-Vorschrift "Grundsätze der Prävention" (BGV A1), Abschnitt "Arbeitsmedizinische Vorsorge" (in Vorbereitung) entsprechende Anhaltspunkte für eine Entscheidung angeboten werden.
Arbeitsmedizinische Vorsorgeuntersuchungen sind in der Metallindustrie nur für einige wenige Tätigkeitsbereiche erforderlich, auf die im Folgenden bei der Beschreibung der einzelnen Arbeitsbereiche näher eingegangen wird.
In der Regel kann davon ausgegangen werden, dass auch bei Zuordnung einer Tätigkeit mit biologischen Arbeitsstoffen in die Schutzstufe 2 unter Einhaltung der erforderlichen Schutzmaßnahmen keine erhöhte Infektionsgefährdung besteht und eine arbeitsmedizinische Vorsorgeuntersuchung nicht angeboten werden muss.
5 Gefährdungsbeurteilung und Schutzmaßnahmen bei Mischexpositionen
5.1 Allgemeine Vorgehensweise
Bei der überwiegenden Mehrzahl der nicht gezielten Tätigkeiten mit biologischen Arbeitsstoffen besteht ein Kontakt zu einem Gemisch von Mikroorganismen unterschiedlicher Risikogruppen, wobei die Kombination aus Organismen der Risikogruppen 1 und 2 am häufigsten auftritt.
Auch die Mikroorganismen, mit denen wir täglich außerberuflich Kontakt haben, stellen im Allgemeinen eine Mischpopulation aus Bakterien, Pilzen und Viren dieser beiden Risikogruppen dar. Ein Kontakt hierzu bedeutet nicht zwingend eine Infektion. Bei reduzierter Immunabwehr oder bei Exposition gegenüber hohen Konzentrationen kann aber eine Erkrankung die Folge sein.
Die Entscheidung, ob eine Mischexposition gegenüber biologischen Arbeitsstoffen der Risikogruppen 1 - und 2 der Schutzstufe 1 oder der Schutzstufe 2 zugeordnet wird, muss der Unternehmer in jedem Einzelfall nach Abschätzung des Infektionsrisikos treffen. Hierzu sollen im Anschluss einige allgemeine Hilfestellungen gegeben werden.
Für ein nicht zu vernachlässigendes Infektionsrisiko und damit für eine Zuordnung der Tätigkeit zur Schutzstufe 2 sprechen
Untersuchungen oder Literaturstellen, die ein häufiges Vorhandensein von Risikogruppe-2-Mikroorganismen belegen (z.B. in wassergemischten Kühlschmierstoffen, Fahrzeugwaschanlagen oder
In Fällen, in denen die genannten Risikofaktoren vernachlässigt werden können, kann eine Zuordnung der Tätigkeit zur Schutzstufe 1 erfolgen.
Fällt die Entscheidung für die Schutzstufe 2, bedeutet dies, dass ein gewisses gesundheitliches Risiko bei der Tätigkeit gesehen wird und dass entsprechende Schutzmaßnahmen daraus abzuleiten und einzuhalten sind.
Häufig besteht im Betrieb eine hohe Hemmschwelle, eine Tätigkeit der Schutzstufe 2 zuzuordnen, aus Angst vor einer großen Anzahl neu umzusetzender Maßnahmen. Viele dieser Maßnahmen sind schon aufgrund anderer Gefährdungen umgesetzt, sodass eine Entscheidung für Schutzstufe 2 nicht zwangsläufig zusätzliche Maßnahmen erforderlich macht.
infrage.
Bei Schutzstufe 2 muss der Unternehmer den Beschäftigten Vorsorgeuntersuchungen anbieten, es sei denn, aufgrund der getroffenen Schutzmaßnahmen ist nicht mit einer gesundheitlichen Gefährdung zu rechnen. Bei Einhaltung geeigneter und wirksamer Schutzmaßnahmen ist davon auszugehen, dass keine über das allgemeine Maß hinausgehende Gefährdung besteht.
Eine Kennzeichnungspflicht bei Schutzstufe 2 besteht nur, wenn sich hieraus eine Verringerung der Gefährdung ergibt. Ist der Kontakt mit dem Arbeitsstoff durch den Arbeitsprozess vorgegeben und nicht zu vermeiden, vermindert auch eine Kennzeichnung diesen Kontakt nicht.
Es ist ersichtlich, dass die Entscheidung für Schutzstufe 1 oder für Schutzstufe 2 bei vielen nicht gezielten Tätigkeiten mit einem nicht näher charakterisierten Gemisch von biologischen Arbeitsstoffen der Risikogruppen 1 und 2 nur einen sehr geringen Unterschied bezüglich der tatsächlich geeigneten Schutzmaßnahmen zur Folge hat. Bei Entscheidung für Schutzstufe 2 stellt sich hauptsächlich die zusätzliche Frage, ob die festgelegten und durchgeführten Schutzmaßnahmen geeignet sind, die Gesundheitsgefahr so weit zu reduzieren, dass eine arbeitsmedizinische Vorsorgeuntersuchung nicht angeboten werden muss.
Unabhängig von der Zuordnung zu Schutzstufe 1 oder 2 müssen zusätzliche Schutzmaßnahmen bei gleichzeitigem Auftreten von biologischen Arbeitsstoffen mit sensibilisierenden oder toxischen Wirkungen getroffen werden.
5.2 Wässrige Umlaufsysteme
Wässrige Systeme sind häufig mit Bakterien und/oder Pilzen besiedelt, da durch die Feuchtigkeit bereits eine Grundvoraussetzung für mikrobiellen Befall gegeben ist. Zusätzlich wird ein Wachstum von anderen Randbedingungen (Nährstoffangebot, Temperatur, pH-Wert, Biozidgehalt [Bild 5-1]) beeinflusst (vgl. Abschnitt 1.1.1).
Bild 5-1: Wachstumsbedingungen für biologische Arbeitsstoffe
| Parameter | Einfluss | Beispiele für Arbeitsbereiche/Verfahren | |
| mit | ohne/geringe | ||
| Besiedlung durch biologische | |||
| Wasser, Feuchtigkeit |
zwingende Voraussetzung für mikrobielles Wachstum | Anwendung wassergemischter Kühlschmierstoffe | Einsatz nicht wassermischbarer Kühlschmierstoffe |
| Nährstoffe | zwingende Voraussetzung für mikrobielles Wachstum | Wasserberieselte Farbnebelabsaugwände | in der Praxis nicht anzutreffen (teilweise reichen sehr niedrige Nährstoffkonzentrationen aus, z.B. in VE-Wasser) |
| Temperatur | optimaler Temperaturbereich für die meisten Bakterien/Pilze: 20 bis 40°C | Hochdruckreinigung mit wässrigen Medien | Reinigung mit Dampfstrahler (> 80°C) |
| pH-Wert | ca. pH 3 bis 10; optimaler pH-Wert um den Neutralpunkt | wässriger Neutralreiniger | wässrige, (heiße) alkalische Teilereinigung (pH 13) |
| Biozidgehalt | bei Unterschreiten der minimalen Hemmkonzentration mangelhafte Biozid-Wirkung | nicht konserviertes Befeuchterwasser in raumlufttechnischen Anlagen (RLT) | sachgemäß konserviertes Befeuchterwasser(z.B. Wasserstoffperoxid mit Metallkatalysator) |
Bei den wässrigen Reinigungssystemen sind z.B. nur diejenigen von einer möglichen Keimbelastung betroffen, die aufgrund des pH-Wertes (etwa pH 3 bis pH 10) ein Wachstum von Mikroorganismen überhaupt zulassen. Je weiter der pH-Wert im sauren bzw. alkalischen Milieu liegt, umso geringer wird die Anzahl der Mikroorganismenarten, die dort noch geeignete Lebensbedingungen vorfinden. Lediglich wenige "Spezialisten" können unter solch extremen Voraussetzungen noch existieren.
Wie Untersuchungen gezeigt haben, werden die meisten technischen, wässrigen Umlaufsysteme mit geeigneten Wachstumsbedingungen für Mikroorganismen von einer Mischpopulation aus Bakterien und/oder Schimmelpilzen/Hefen der Risikogruppen 1 und 2 besiedelt.
Im Rahmen der Gefährdungsbeurteilung sind genaue Bestimmungen bis zur Art nicht sinnvoll, da sich die Menge und Artenzusammensetzung der Keime rasch ändern kann. Derartige Bestimmungen sind daher im Regelfall auch nicht erforderlich.
Bei der Gefährdungsbeurteilung kann man entsprechend Abschnitt 5.1 vorgehen.
Im Regelfall reichen die in der TRBa 500 genannten und unter Abschnitt 3.2.2 dieser Broschüre ausführlich beschriebenen Schutzmaßnahmen aus, um eine Gefährdung der Beschäftigten zu minimieren.
In sehr vielen Fällen sind die nach BioStoffV festgelegten Schutzmaßnahmen bereits unter anderen Arbeitsschutzaspekten umgesetzt worden, beispielsweise die regelmäßige Wartung und Pflege von wassergemischten Kühlschmierstoffen nach BG-Regel "Tätigkeiten mit Kühlschmierstoffen" (BGR 143) bzw. BG-Information "Keimbelastung wassergemischter Kühlschmierstoffe" (BGI 762).
5.2.1 Tätigkeiten mit wassergemischten Kühlschmierstoffen
Beschreibung
Wassergemischte Kühlschmierstoffe werden bei der Metallzerspanung und -umformung als Hilfsstoffe eingesetzt (Bild 5-2). Die Anwendungspalette reicht von der offenen Anwendung an ungekapselten Maschinen mit entsprechenden Expositionsmöglichkeiten der Beschäftigten bis hin zu weitgehend gekapselten und mit Absaugungen versehenen Maschinen mit nur sehr geringer Kontaktmöglichkeit zum verwendeten Kühlschmierstoff.
Bild 5-2: Schleifen von Wälzlagerringen

Gefährdungsbeurteilung
Aufgrund ihrer Zusammensetzung unterliegen wassergemischte Kühlschmierstoffe bei der Anwendung zwangsläufig einer mikrobiellen Besiedlung. Tätigkeiten mit keimbelasteten wassergemischten Kühlschmierstoffen stellt daher eine nicht gezielte Tätigkeit mit biologischen Arbeitsstoffen im Sinne der BioStoffV dar.
Von der Arbeitsgruppe "Biologische Arbeitsstoffe" des Fachausschusses Maschinenbau, Fertigungssysteme, Stahlbau wurde die BG-Information "Keimbelastung wassergemischter Kühlschmierstoffe" (BGI 762) erarbeitet, welche dem Unternehmer die i nach BioStoffV notwendige Gefährdungsbeurteilung erleichtert und außerdem konkrete Schutzmaßnahmen empfiehlt.
In Betriebsproben von wassergemischten Kühlschmierstoffen wurden neben Mikroorganismen der Risikogruppe 1 auch häufig Bakterien und Schimmelpilze/Hefen der Risikogruppe 2 nachgewiesen (Bild 5-3).
Es handelt sich somit um eine Mischexposition gegenüber Risikogruppe-1- und -2-Organismen, für die der Ablauf der Gefährdungsbeurteilung unter Abschnitt 5.1 erläutert ist.
Neben einer möglichen Infektionsgefahr bestehen Gesundheitsgefährdungen durch sensibilisierende Wirkungen, vorwiegend bei schlecht gewarteten und mit Schimmelpilzen befallenen Systemen. Toxische Effekte können durch Endotoxine oder ähnlich wirkende Substanzen auftreten, die vorwiegend beim Absterben bestimmter Bakterien freigesetzt werden.
Bild 5-3: Biofilm auf einem wassergemischten Kühlschmierstoff

Den Berufsgenossenschaften ist zwar bisher keine Häufung von Infektionskrankheiten durch den Umgang mit wassergemischten Kühlschmierstoffen gemeldet worden. Dennoch wird in den meisten Fällen die Tätigkeit der Schutzstufe 2 zuzuordnen sein, da aufgrund des vorhandenen Artenspektrums, der Übertragungswege (Aerosole und Hautkontakt) und der vorhandenen Konzentrationen der biologischen Arbeitsstoffe eine Infektion nicht ausgeschlossen werden kann.
Maßnahmen
Die konkreten Schutzmaßnahmen zur Minimierung einer Gefährdung durch biologische Arbeitsstoffe sind weitgehend identisch mit denen zur Verminderung der Belastung durch Gefahrstoffe. Diese werden in der TRGS 611 und der BGR 143 ausführlich beschrieben.
Die Maßnahmen konzentrieren sich auf
Zusätzlich empfiehlt die BGI 762, nur keimarmes Ansetzwasser (Trinkwasserqualität) zu verwenden.
Möglichkeiten der Vermeidung von Tätigkeiten mit wassergemischten Kühlschmierstoffen bestehen in der Trockenbearbeitung, der Anwendung von Minimalmengenschmierung und dem Einsatz von nicht wassermischbaren Kühlschmierstoffen. Die Tätigkeit fällt dann nicht in den Anwendungsbereich der BioStoffV.
Zusammenfassend kann festgehalten werden, dass nach derzeitigem Wissensstand bei Einhaltung aller bereits bestehenden Vorschriften und Regelungen für den Bereich der Kühlschmierstoff-Anwendung ( GefStoffV, TRGS 611, TRGS 900, BGR 143, BGI 762) die Schutzmaßnahmen der Schutzstufe 2 erfüllt sind.
Arbeitsmedizinische Vorsorgeuntersuchungen
Arbeitsmedizinische Vorsorgeuntersuchungen müssen beim Umgang mit wassergemischten Kühlschmierstoffen nur dann angeboten werden, wenn die getroffenen Schutzmaßnahmen nicht hinreichend wirksam sind. Die neue GefStoffV sieht jedoch Angebotsuntersuchungen für Feuchtarbeiten ab zwei Stunden pro Tag vor, ab vier Stunden sogar Pflichtuntersuchungen (entsprechend dem berufsgenossenschaftlichen Grundsatz G 24).
5.2.2 Einsatz von Neutralreinigern Beschreibung
Wässrige Neutralreiniger werden zunehmend zur Reinigung von Leichtmetallen, z.B. Aluminium- oder Magnesiumlegierungen, eingesetzt. Aufgrund des neutralen pH-Bereichs bieten sie für die meisten Mikroorganismen ideale Wachstumsvoraussetzungen. Dem Vorteil einer guten biologischen Abbaubarkeit der Reiniger steht damit der Nachteil eines unerwünschten mikrobiellen Befalls mit verkürzter Standzeit und möglichen Gesundheitsgefährdungen der Beschäftigten entgegen.
Relativ neu auf dem Markt sind so genannte "Pinselwaschtische" (Bild 5-4) auf wässriger Basis mit dem Zusatz von Mikroorganismen. Diese "biologischen Teilereiniger" sind frei von organischen Lösemitteln und reduzieren somit die Luftbelastung im Arbeitsbereich und auch die Brandgefahr. Waschaktive Substanzen dienen als neutrales Reinigungsmedium. Die von Herstellerseite zugesetzten Bakterien der Risikogruppe 1 (Bescheinigung des Herstellers) sollten Fette und Öle abbauen und so zu einer Standzeitverlängerung des Reinigungsmediums führen. Stichproben-artige Untersuchungen von Betriebsproben zeigen jedoch, dass bereits nach kurzer Standzeit auch Mikroorganismen der Risikogruppe 2 eingeschleppt wurden.
Bild 5-4: "Biologischer Teilereiniger" (Pinselwaschtisch)

Die Reinigungswirkung ist im Vergleich zu konventionellen wässrigen Neutralreinigern durch die erhöhte Temperatur des Waschmediums (37 °C) verbessert.
Gefährdungsbeurteilung
Tätigkeiten mit mikrobiell belasteten Neutralreinigern sind nicht gezielte Tätigkeiten im Sinne der BioStoffV. In wässrigen Reinigern siedeln sich wie in allen wässrigen Systemen Mikroorganismen der Risikogruppen 1 und 2 an (siehe hierzu auch Abschnitt 5.2).
Mögliche Gesundheitsgefährdungen können vor allem durch Einatmen oder direkten Hautkontakt mit dem keimbelasteten Reiniger entstehen. Dies ist z.B. der Fall, wenn es sich bei den Reinigungstätigkeiten um Dauerarbeitsplätze handelt oder bei Instandhaltungsarbeiten innerhalb gekapselter Anlagen (z.B. Filterreinigung). Auch sind entzündliche Atemwegsreaktionen durch Endotoxine (siehe Abschnitte 1.1.2 und 1.2.2) nicht ausgeschlossen.
Einige Teilereinigungsanlagen ("Waschmaschinen") sind nicht vollautomatisiert und/oder gekapselt und müssen noch von Hand bestückt und entladen werden. Dabei ist es nicht ausgeschlossen, dass der Beschäftigte Kontakt zum Reinigungsmittel hat und besonders beim Öffnen der Maschine, nach Beendigung des Reinigungsvorganges, auch mikrobiell belasteten Aerosolen ausgesetzt ist.
Tätigkeiten an solchen manuell betriebenen und nicht abgesaugten Reinigungsanlagen sind daher der Schutzstufe 2 nach BioStoffV zuzuordnen.
Bei so genannten Heißreinigern wird die Reinigungsflüssigkeit auf etwa 65 °C erhitzt. Dadurch wird die Anzahl der Mikroorganismen zwar automatisch reduziert, aber auch bei diesen Temperaturen können noch bestimmte Bakterienarten (z.B. thermophile [= wärmeliebende] Actinomyceten) überleben, aufgrund ihrer Fähigkeit → Sporen als widerstandsfähige Dauerformen auszubilden.
Auch Tätigkeiten an Pinselwaschtischen sind nicht gezielte Tätigkeiten im Sinne der BioStoffV. Mikrobiologische Untersuchungen der im Einsatz befindlichen Reinigungsflüssigkeit zeigten, dass sich wie bei allen wässrigen Reinigungssystemen eine Mischpopulation aus Mikroorganismen der Risikogruppen 1 und 2 ansiedelt. Die zur "biologischen Reinigung" zugesetzten Mikroorganismen waren dahingegen in den untersuchten Proben nicht nachweisbar.
Maßnahmen
Zur Vermeidung bzw. Reduzierung einer starken Aerosolbildung sollten Teilereinigungsanlagen möglichst gekapselt sein und/oder über eine geeignete Absaugung (Schwadenkondensatoren) verfügen.
Das Reinigungsmedium und die Anlage müssen regelmäßig gewartet und gepflegt werden.
Bei Instandhaltungsarbeiten innerhalb gekapselter Anlagen sollten flüssigkeitsdichte Schutzhandschuhe und ggf. Atemschutz (bei Aerosolbildung) und Schutzkleidung benutzt werden.
Bei Tätigkeiten an Pinselwaschtischen mit wässrigen Reinigungsmedien kommt es in aller Regel zu einem intensiven Hautkontakt mit der Reinigungsflüssigkeit. Aufgrund der entfettenden Wirkung müssen geeignete Schutzhandschuhe getragen werden, die auch die mögliche Gefahr einer Hautinfektion verhindern.
Darüber hinaus ist bei regelmäßigen und längerfristigen Reinigungstätigkeiten eine "Gefährdung der Haut durch Arbeiten im feuchten Milieu (Feuchtarbeit)" zu berücksichtigen und die TRGS 531 zu beachten.
Arbeitsmedizinische Vorsorge
Arbeitsmedizinische Vorsorgeuntersuchungen müssen bei Tätigkeiten mit mikrobiell belasteten Neutralreinigern nur dann angeboten werden, wenn die getroffenen Schutzmaßnahmen nicht hinreichend wirksam sind.
Bei Feuchtarbeit von regelmäßig vier Stunden oder mehr pro Tag ist eine arbeitsmedizinische Pflichtuntersuchung nach GefStoffV vom Unternehmer zu veranlassen, bei Feuchtarbeit von regelmäßig mehr als zwei Stunden eine Vorsorgeuntersuchung anzubieten ( GefStoffV, Anhang V, Nr. 2).
5.2.3 Wasserberieselte Farbnebelabsaugwände
Beschreibung
Zum Abscheiden von Farbaerosolen beim Farbspritzen werden häufig wasserberieselte Farbnebelabsaugwände (Bild 5-5) eingesetzt. Die nicht am Werkstück anhaftenden Farbtröpfchen werden durch eine gerichtete Luftströmung erfasst und durch Aufprall auf wasserumströmte Bleche im Umlaufwasser abgeschieden.
Um einen störungsfreien Betrieb zu gewährleisten, werden dem Umlaufwasser unterschiedliche Chemikalien, wie Flockungsmittel und Biozide, zugegeben.
Bild 5-5: Farbnebelabsaugwand

Der Betrieb erfolgt meist unregelmäßig, sodass das Umlaufsystem in arbeitsfreier Zeit (nach Schichtende, am Wochenende) nicht bewegt wird.
Gefährdungsbeurteilung
In den Umlaufwässern werden Mikroorganismen der Risikogruppen 1 und 2 gefunden, sodass sich die Gefährdungsbeurteilung am Abschnitt 5.1 orientieren kann. In der Regel handelt es sich um nicht gezielte Tätigkeiten der Schutzstufe 2. Gefährdet ist jedoch weniger der Spritzlackierer selbst, da dieser in den meisten Fällen ohnehin aufgrund der Gefahrstoffproblematik Atemschutz trägt, sondern vielmehr derjenige, der Reinigungs- und Wartungsarbeiten am Abscheider durchführt.
Maßnahmen
Eine starke Verkeimung der Abscheider tritt vorwiegend bei unzureichender Pflege auf, wenn beispielsweise die nötigen Zusätze zum Umlaufwasser nur sporadisch zudosiert werden, sodass die beste Methode zur Verringerung einer Gefährdung durch biologische Arbeitsstoffe in einer regelmäßigen und sorgfältigen Wartung und Pflege besteht.
Insbesondere wenn nach Stillstandzeiten faulige Gerüche auftreten, ist dies ein Zeichen für eine starke Besiedlung des Systems mit Bakterien; neben den in der Praxis üblichen Biozidzugaben (Vorsicht: sachkundiges Personal erforderlich!) kann hier eine Belüftung durch Umwälzung auch in arbeitsfreier Zeit Abhilfe schaffen.
Zur Minimierung der Gefährdung bei der Reinigung und Wartung der Anlagen sollten hier neben Beachtung der allgemeinen Hygienemaßnahmen der TRBa 500 geeignete persönliche Schutzausrüstungen in Form von feuchtigkeitsdichten Kunststoffhandschuhen, Gummischürze und Gesichtsschutz getragen werden.
Bei bereits sichtbarem starken Schimmelpilzbefall sollte darüber hinaus Atemschutz (P3-Filter, bei kurzfristigen Arbeiten P2-Filter) getragen werden.
5.2.4 Fahrzeugwaschanlagen Beschreibung
Betriebliche und gewerbliche Fahrzeugwaschanlagen stellen in aller Regel kreislaufgeführte wässrige Systeme dar. Das Fahrzeugwaschwasser wird mit Hilfe physikalischer, chemischer und/oder biologischer Verfahren aufbereitet und wiederverwendet. Die Aufbereitung dient vorwiegend dem Entfernen von Schmutzpartikeln, Ölresten und anderen Verunreinigungen. Bei dem aufbereiteten Wasser handelt es sich somit um Brauchwasser, das einer Besiedlung mit Mikroorganismen unterliegt.
Gefährdungsbeurteilung
Arbeiten mit Kontakt zu Fahrzeugwaschwasser sind nicht gezielte Tätigkeiten im Sinne der BioStoffV. Untersuchungen haben gezeigt, dass die im Waschwasser vorkommenden Bakterien, Hefen und Schimmelpilze den Risikogruppen 1 und 2 angehören.
Die Gesamtkoloniezahl des Waschwassers liegt durchschnittlich im Bereich zwischen 105 bis 106 KBE/ml; Bakterien dominieren, Schimmelpilze spielen keine, Hefen nur eine untergeordnete Rolle.
Häufig in der Diskussion stehende Mikroorganismen, wie Salmonellen, Legionellen oder Candida albicans (Hefepilz), konnten in Untersuchungen nicht nachgewiesen werden.
Anlagen mit biologischer Aufbereitung (z.B. Belebungsbecken, Füllkörper) zeigen keine höhere mikrobielle Belastung als Anlagen mit anderen Aufbereitungsverfahren. Ein unerwünschter zusätzlicher Eintrag von Mikroorganismen in das Waschwasser findet somit nicht statt.
Bild 5-6: Fahrzeugwaschanlage

Bei Tätigkeiten in Fahrzeugwaschanlagen können Beschäftigte mit mikrobiell belastetem Waschwasser oder entsprechend benetzten Anlagenteilen in Kontakt kommen, z.B. bei
Durchgeführte Luftmessungen in Fahrzeugwaschanlagen zeigten weiterhin, dass die Luft im Arbeitsbereich der Waschanlage im Vergleich zur Außenluft höher mit Bakterien belastet ist. Durch den Waschprozess werden folglich hauptsächlich Bakterien aus dem Waschwasser als Bioaerosol in die Luft eingetragen. Die im Arbeitsbereich nachgewiesenen Schimmelpilze sind in Art und Menge weitgehend identisch mit denen in der Außenluft.
Daher sind alle Tätigkeiten, die mit einer starken Aerosolbildung verbunden sind oder im Bereich einer starken Vernebelung von mikrobiell belastetem Brauchwasser erfolgen, der Schutzstufe 2 zuzuordnen. Alle anderen Tätigkeiten können der Schutzstufe 1 zugeordnet werden.
Beispiele für nicht gezielte Tätigkeiten der Schutzstufe 2:
Schutzmaßnahmen
Als grundsätzliche Maßnahmen sind die in der TRBa 500 genannten Hygieneregeln zu nennen.
Manuell betriebene Hochdruckreiniger, z.B. zur Vorreinigung von Fahrzeugen, dürfen nur mit Trinkwasser befüllt bzw. betrieben werden.
Sofern die Geräte über längere Zeit nicht genutzt werden, ist darauf zu achten, dass im Gerät vorhandene Wasserreservoirs vollständig entleert werden.
Dauerarbeitsplätze sollten nicht im Bereich der Waschhalle mit starken Vernebelungen von Brauchwasser (Bioaerosolbildung) eingerichtet sein.
Bei Service-, Reinigungs- und Instandhaltungsarbeiten in Fahrzeugwaschanlagen mit Gefahr einer Durchnässung ist auf feuchtigkeitsdichte persönliche Schutzausrüstungen zu achten.
Bei starker Vernebelung von Brauchwasser, beispielsweise bei Wartungs- und Reparaturarbeiten an laufenden Anlagen sowie bei der Gefahr von Spritzwasserbildung, sollten zusätzlich auch Schutzbrille und Atemschutzmaske (P2-Filter) getragen werden.
Arbeitsmedizinische Vorsorge
Bei Einhaltung der genannten Schutzmaßnahmen ist nicht von einer Infektionsgefährdung auszugehen, demzufolge ist eine arbeitsmedizinische Vorsorge nach BioStoffV nicht erforderlich. Darüber hinaus liegen keine Hinweise auf eine Häufung von Infektionskrankheiten oder Allergien bei Fahrzeugreinigern und Fahrzeugpflegern vor.
Weitere Informationen enthalten der Ergebnisbericht der mikrobiologischen Untersuchungsreihen von Betriebswasser in Fahrzeugwaschanlagen und die Broschüre "Fahrzeugwaschanlagen - Handlungshilfe zur Umsetzung der Biostoffverordnung" (siehe Abschnitt 7.2.7 "Sonstige Literatur").
5.2.5 Andere wässrige Umlaufsysteme
Neben den wassergemischten Kühlschmierstoffen finden sich auch andere wässrige Umlaufsysteme in der Metall be- und -verarbeitenden Industrie sehr häufig:
Bei den wässrigen Reinigungssystemen sind nur diejenigen von einer möglichen Verkeimung betroffen, die aufgrund des pH-Wertes (ca. zwischen pH 3 und pH 10) ein Keimwachstum überhaupt zulassen.
Neben den Teilereinigungsanlagen sind hier vor allem Fahrzeugwaschanlagen zu nennen, die aus Gründen des Umweltschutzes heute zum großen Teil mit kreislaufgeführtem Wasch- und Spülwasser arbeiten und in Abschnitt 5.2.4 ausführlich behandelt werden.
Bei Tätigkeiten in anderen Bereichen kann sich der Unternehmer an bereits bestehenden, vergleichbaren Regelungen orientieren. Beispielsweise ist der Umgang mit wässrigen Abschreckmedien beim Härten von Stahl sowohl von der Zusammensetzung der Medien als auch von den Expositionsmöglichkeiten vergleichbar einem Kontakt zu wassergemischten Kühlschmierstoffen. Hier bietet sich also an, bei der Gefährdungsbeurteilung einen Blick auf das vergleichbare Thema zu werfen.
Bild 5-7: Induktivhärten mit wässrigen Abschreckmedien

Bild 5-8: Kühlturm mit Metalkatalysatoren

5.3 Instandhaltungsarbeiten
Viele Betriebe der Metallbranche führen regelmäßig Instandhaltungsarbeiten in biologisch kontaminierten Bereichen aus. Die Bandbreite der Tätigkeiten und damit auch die Vielfalt der möglichen biologischen Arbeitsstoffe ist sehr groß und soll im Folgenden etwas näher betrachtet werden.
Sie erstreckt sich von Bereichen der Lebensmittelproduktion mit hohen innerbetrieblichen Hygienestandards bis hin zu Arbeiten im Abfall- oder Abwasserbereich.
Gemeinsam ist all diesen Tätigkeiten, dass sie "nicht gezielt" sind. Sie können entweder durch betriebsinterne Instandhalter oder durch Fremdunternehmen ausgeführt werden. Bei der Beauftragung von Fremdunternehmen ergeben sich in der Praxis häufig zusätzliche Probleme bei der Informationsbeschaffung und bei der Durchführung notwendiger Maßnahmen (siehe Abschnitt 3.4).
Bei Instandhaltungsarbeiten können Gefährdungen häufig nicht durch technische und organisatorische Maßnahmen vermieden werden; dies kann oft nur durch den Einsatz persönlicher Schutzausrüstungen erreicht werden. Der persönlichen Hygiene kommt daher eine besondere Bedeutung zu.
Für Instandhaltungstätigkeiten im Außendienst hat sich der Einsatz eines "Hygienekoffers" bewährt. Der Inhalt muss den speziellen Anforderungen des Einsatzbereiches angepasst sein.
Zur Grundausstattung können gehören:
5.3.1 Instandhaltung von Abfallsortieranlagen, Kompostieranlagen und Anlagen zur thermischen Abfallbehandlung oder Abfallverwertung
Beschreibung
Mit der Einführung des dualen Systems wurde in Deutschland die Abfallsortierung im großen Umfang erforderlich. Schimmelpilze und Bakterien finden durch anhaftende Reste an Verpackungen (Bild 5-9) und hohe Feuchtigkeit in den "gelben Säcken" oder "gelben Tonnen" nahezu ideale Wachstumsbedingungen. Daneben gefährden so genannte "Fehlwürfe" (z.B. Babywindeln, Hygieneartikel) die Gesundheit derjenigen, welche die Verpackungen manuell in die unterschiedlich zu recycelnden Rohstoffe trennen.
Betriebe der Metallbranche führen in Abfallsortieranlagen oder Kompostieranlagen Instandhaltungsarbeiten aus.
Anlagen zur thermischen Abfallbehandlung können sowohl herkömmliche Müllverbrennungsanlagen als auch industrielle Feuerungsanlagen (Zementwerke, Kraftwerke) sein. In vielen Müllverbrennungsanlagen wird vorwiegend Restmüll aus privaten Haushalten (gemischte Siedlungsabfälle) verbrannt. In dafür zugelassenen Anlagen können aber auch andere Abfälle, beispielsweise aus Abwasserbehandlungsanlagen (Rechengut, Klärschlamm) oder aus dem Gesundheitswesen (mit Blut, Sekreten bzw. Exkreten behaftete Abfälle, wie Wundverbände, Gipsverbände, Einwegwäsche, Stuhlwindeln, Einwegartikel usw.), als Brennstoff eingesetzt werden.
"Infektiöse Abfälle" (z.B. aus der Pflege und Behandlung von Personen mit ansteckungsgefährlichen Krankheiten oder aus Laboratorien, in denen Umgang mit l infektiösen Erregern besteht) sind besonders überwachungsbedürftige Abfälle und werden nur in spezielle, für diese Zwecke ausgelegte und zugelassene Anlagen eingebracht.
Bild 5-9: Aussortierte Fraktion aus Verpackungsabfällen

Gefährdungsbeurteilung
Durch das Sortier- oder Kompostiergut treten in verschiedenen Arbeitsbereichen von Abfallsortier- und Kompostieranlagen Schimmelpilze und Bakterien der Risikogruppen 1 und 2 auf. Besonders bei inhalativer Aufnahme muss zusätzlich ein sensibilisierendes und toxisches Potenzial berücksichtigt werden. Durch unzulässige Fehlwürfe können Fäkalien oder Abfälle aus dem Gesundheitsdienst zusätzliche Gefährdungen verursachen.
Mit der TRBa 210 "Abfallsortieranlagen: Schutzmaßnahmen" und TRBa 211 "Biologische Abfallbehandlungsanlagen: Schutzmaßnahmen" sind Handlungshilfen erlassen worden, die Hilfestellung für die Gefährdungsbeurteilung in diesen Bereichen geben und die darüber hinaus konkrete Schutzmaßnahmen vorgeben.
In Anlagen zur thermischen Abfallbehandlung oder Abfallverwertung kommt es durch die eingesetzten Abfälle in einigen Arbeitsbereichen zu einer Gefährdung durch biologische Arbeitsstoffe. Auch hier stehen Schimmelpilze und Bakterien der Risikogruppen 1 und 2 im Vordergrund. Je nach Herkunft des Abfalls können aber auch biologische Arbeitsstoffe der Risikogruppe 3 enthalten sein.
 |
weiter . |  |
(Stand: 24.07.2025)
Alle vollständigen Texte in der aktuellen Fassung im Jahresabonnement
Nutzungsgebühr: ab 105.- € netto
(derzeit ca. 7200 Titel s.Übersicht - keine Unterteilung in Fachbereiche)
Die Zugangskennung wird kurzfristig übermittelt
? Fragen ?
Abonnentenzugang/Volltextversion